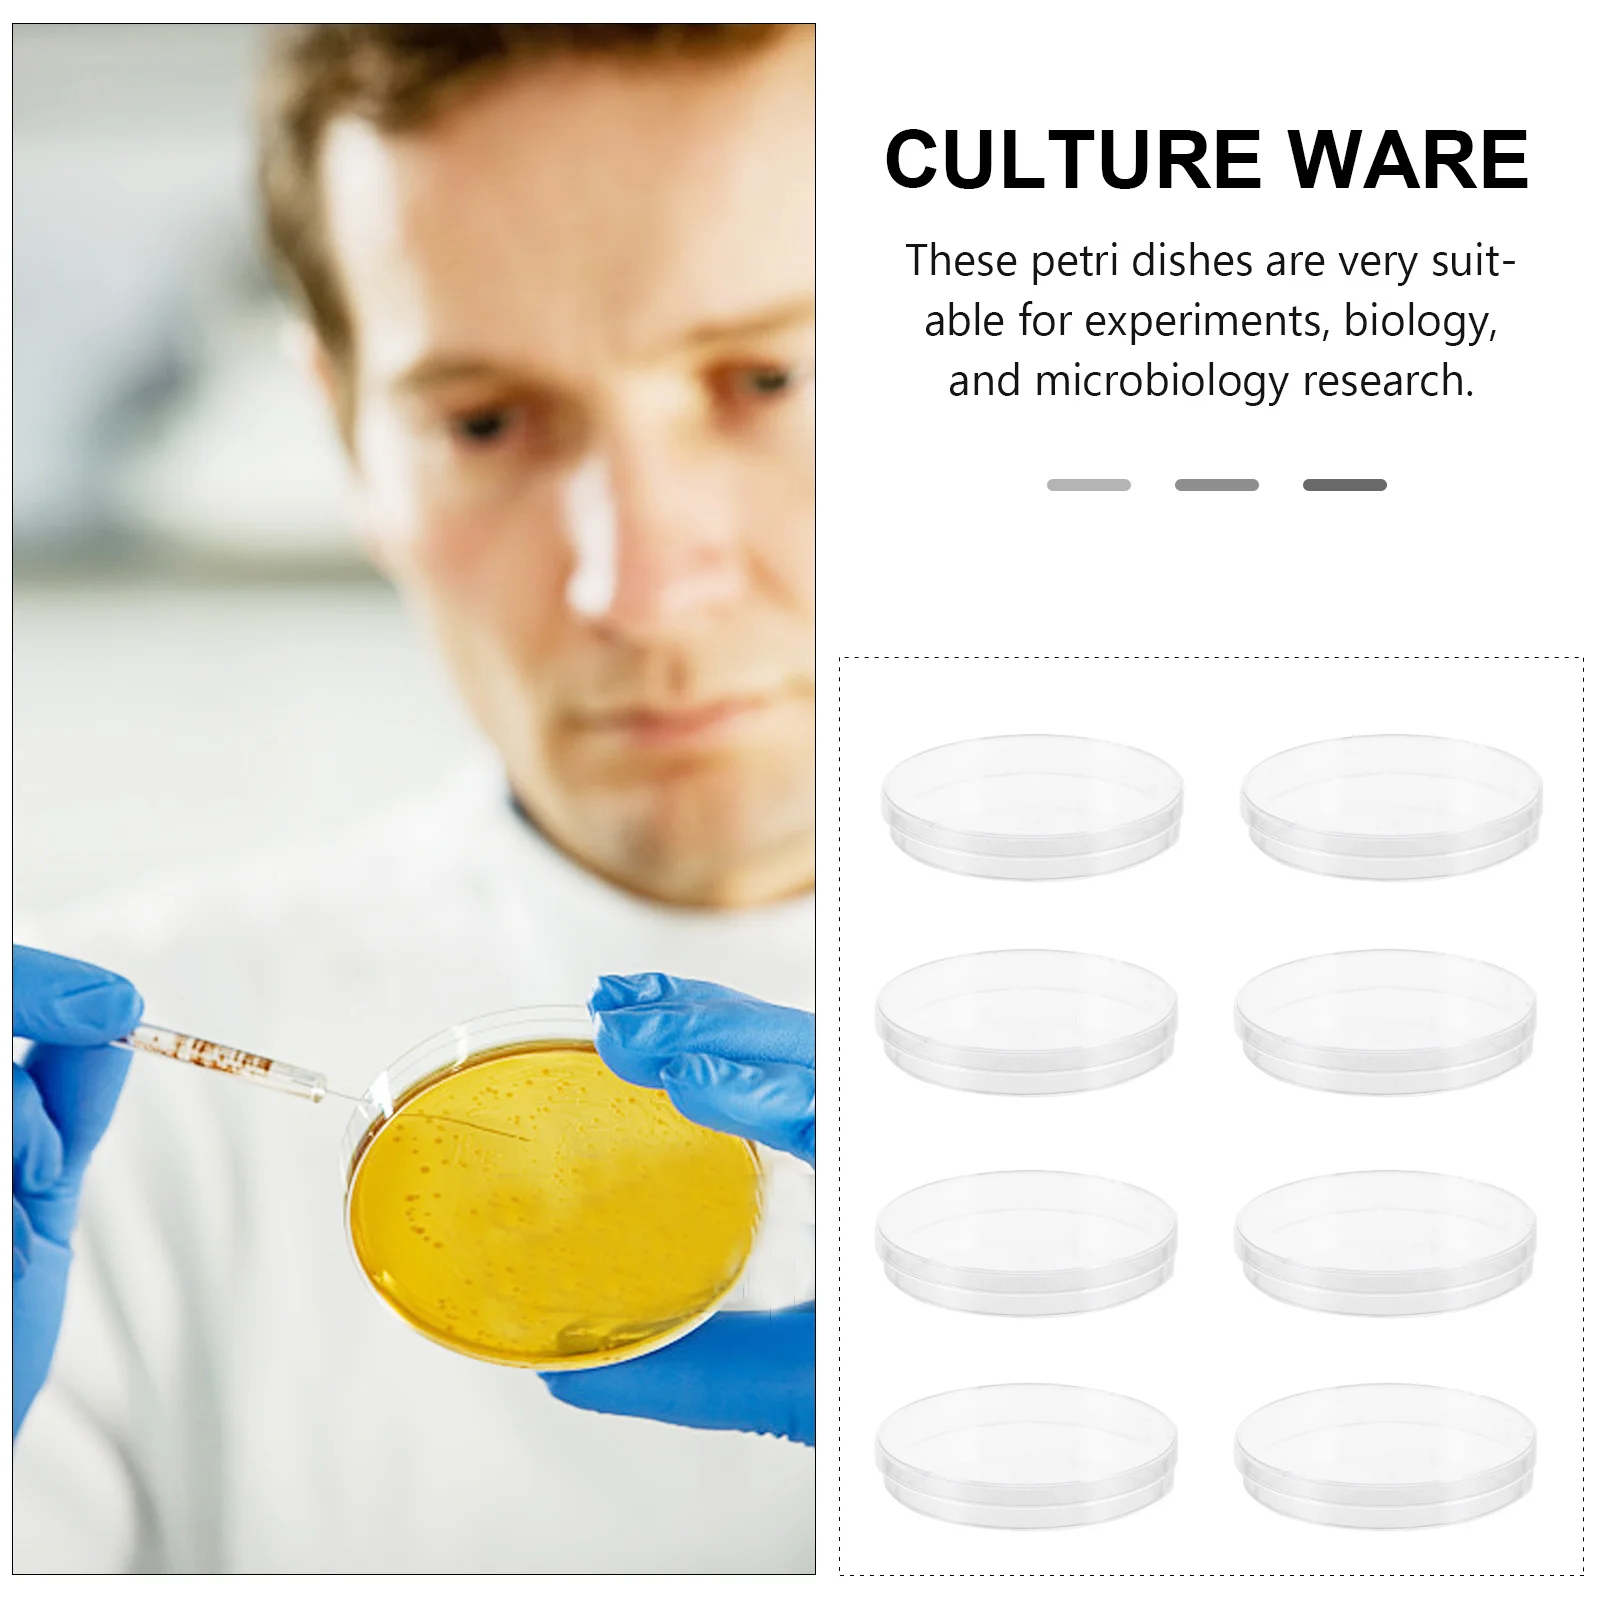
20Pcs Plastic Petri Dishes 90Mm Clear Reusable Sterile Dishes for Science Lab Research Bacterial Culture and Microorganism

Hot Sale 2.4G Wireless Keyboard English Noiseless Ergonomic Ultra Slim Keyboard for Android Phone Tablet PC Computer Desktop














артикул: 32998137112
СОГЛАСНО НАШИМ ДАННЫМ, ЭТОТ ПРОДУКТ СЕЙЧАС НЕ ДОСТУПЕН
$12.59
Доставка из: Китай
Характеристики
| Application: | Tablet,Desktop,Laptop |
| Axis Body Brand: | NO |
| Brand Name: | ZERODATE |
| Full Size keyboard: | No |
| G Mini Keyboard Mouse Set: | for IOS Android Win 7 10 |
| Interface Type: | USB |
| Keyboard Standard: | 78 Keys |
| Language: | English |
| Model Number: | K116 mini Wireless Keyboard |
| Operation Style: | Membrane |
| Package: | Yes |
| Portable Wireless Keyboard: | for Mac Notebook Laptop TV box |
| sku: | I0075 |
| Style: | Standard,Slim,Multimedia,For Laptop,For Tablet |
| Type: | Wireless Keyboard for Mac Notebook Laptop |
| Wrist Support: | No |
График изменения цены & курс обмена валют
Пользователи также просматривали

$328.00
Shoe store stainless steel bag rack wall shoes rack display rack cosmetics shelf men's and women's shoe rack jewelry rack
aliexpress.com
$2,253.94
Side cabinet Solid wood antique door cabinet Italian minimalist storage chest cabinet
aliexpress.com
$6.26
Baby Irish Festival Outfits Letter Embroidery Long Sleeve Round Neck Romper with Long Pants and Hat 3Pcs Set
aliexpress.com
$13.16
Super Specific Design for Shirts T-Shirt anime t shirts man clothes Men's cotton t-shirt
aliexpress.com
$21.97
Летние женские сандалии на высоком каблуке Crystal Queen D'Orsay и двухсекционные белые сандалии на шпильке из искусственной кожи, обувь для вечеринок 7 см
aliexpress.ru
$1.69
Prime Foods Sweet Potato Peri Peri Chips | Crispy Vacuum Fried Chips | Vegan | Gluten Free | Rich in fiber | Healthy Snack | 70 grams Each Pack of 1
hyugalife.com
$214.44
Мужской бежевый свитер в рубчик, свободный крой, с круглым вырезом, для осени и зимы
aliexpress.ru
$27.91
Набор из 1 контейнера для хранения масла на кухне: элегантная масленка с крышкой, идеально подходит для длительного сохранения свежести продуктов
aliexpress.ru
$6.19
Портативный скребок из титановой стали для полировки и удаления пятен с автомобиля, для очистки пленок
aliexpress.ru
$8.22
Инструмент для волос, бисер, хвост, хвост, инструменты для изготовления Topsy, косички, укладка, бусины, плетение, быстрая французская женская автоматическая загрузка
aliexpress.ru
$9.58
Мужская рубашка на День Святого Патрика с 3D-графикой и принтом, зеленая, с пуговицами, пляжная, с коротким рукавом, повседневная, одежда
aliexpress.ru
$36.37
Мужской вязаный свитер-кардиган с объемным нашивным элементом, повседневный, износостойкий, не деформируется
aliexpress.ru
$4.83
Купи 2, получи 2 бесплатно! Капсулы Шиладжит с высокой степенью абсорбции, улучшают память, развитие мышления, повышают иммунитет, для мальчиков и девочек
aliexpress.ru
$6.65
Карты Таро для влюбленных, радужные поцелующие скелеты, рюкзаки, водонепроницаемые школьные сумки для колледжа, ко Дню святого Валентина, сумка для книг с принтом
aliexpress.ru
$29.72
Bburago 1:24 Ferrari Rafah модель автомобиля из сплава, статические украшения, игрушка может подарить в подарок на день рождения для детей
aliexpress.ru
$137.73
Front Rear Lowering Drop Coil Spring Shock Kit Automotive Suspension Upgrade for Chevy C10 1963-1972 Trucks Enhanced Handling
aliexpress.ru
$235.69
Пальто NOEND25 Barn Sle Color Blo Long, свободного кроя, белое, с воротником из натурального пуха, на пуговицах, теплое, модное, женское
aliexpress.ru
$5.71
Kawaii Maneki Neko Socks compression Children's moving stockings Rugby Socks Women's Men's
aliexpress.ru
$58.49
Мужская повседневная куртка-кардиган на весну-осень 2025: новая модная молодежная модель с отложным воротником, однотонная, приталенная, верхняя одежда размера M
aliexpress.ru
$11.81
Мужской пуховый хлопковый жилет Thiened для работы на открытом воздухе, свободный крой, теплый молодежный модный цветной повседневный костюм на молнии
aliexpress.ru
$12.02
Профессиональный тестер тока автомобильных предохранителей с перчаткой CNBJ-611, анализатор утечек тока в автомобиле, тестер неисправностей
aliexpress.ru
$65.40
Классический женский костюм JAM: приталенный пиджак премиум-класса для ранней осени, модный, тонкий, повседневный, деловой стиль
aliexpress.ru
$27.70
Женские сандалии на платформе из искусственной кожи, размер 43, с пряжкой на щиколотке, на толстой подошве, в римском стиле, для пляжа, нескользящие, летние, 2026
aliexpress.ru
$12.46
20Pcs Plastic Petri Dishes 90Mm Clear Reusable Sterile Dishes for Science Lab Research Bacterial Culture and Microorganism
aliexpress.ru
$14.78
48 pcs American Desktop Flag Usa National Flags Polyester Gold Base Mini Stick Flags For Office Home Party Festival
aliexpress.ru
$10.79
Drawer Organizer Box Plastic Multi-Compartment Storage Solution for Desk Dresser Makeup Kitchen Tableware Stationery Household
aliexpress.ru
$5.15
1Set Stainless Steel Cheese Melting Pot Professional Compact Pan for Melting Butter Chocolate Caramel Backpacking Cookware
aliexpress.ru
$4.75
New 3 In 1 Pet Deshedding Brush Dog Hair Remover Pet Fur Knot Cutter Puppy Cat Comb Brushes Dogs Grooming Shedding Supplies
aliexpress.ru
$816.11
Выхлопная система MANX Ti/SS304, высокопроизводительная выхлопная система Catback для Porsche 718 982, обновление 2,0 T GT4, глушитель выхлопного клапана автомобиля
aliexpress.ru
$29.93
Мужские летние спортивные брюки из ледяного шелка, быстросохнущие, для подростков, больших размеров, длиной до колена, повседневные
aliexpress.ru
$11.01
Flower Shaped Pet Feeding Bowl Premium Plastic Multiple Cat Feeder Dog Treats Dispenser Comfortable Neck Position
aliexpress.ru
$49.80
Бесшовный мягкий парик омбре блонд с глубокими волнами, 180% плотность, 26 дюймов, с кружевной передней частью, для женщин, с натуральной линией роста волос и предварительно выщипанными прядями
aliexpress.ru
$119.07
High Quality Wholesale Ultrasonic Bark Stopper Control Device Training Aids Dog Barking Control Devices
aliexpress.com

